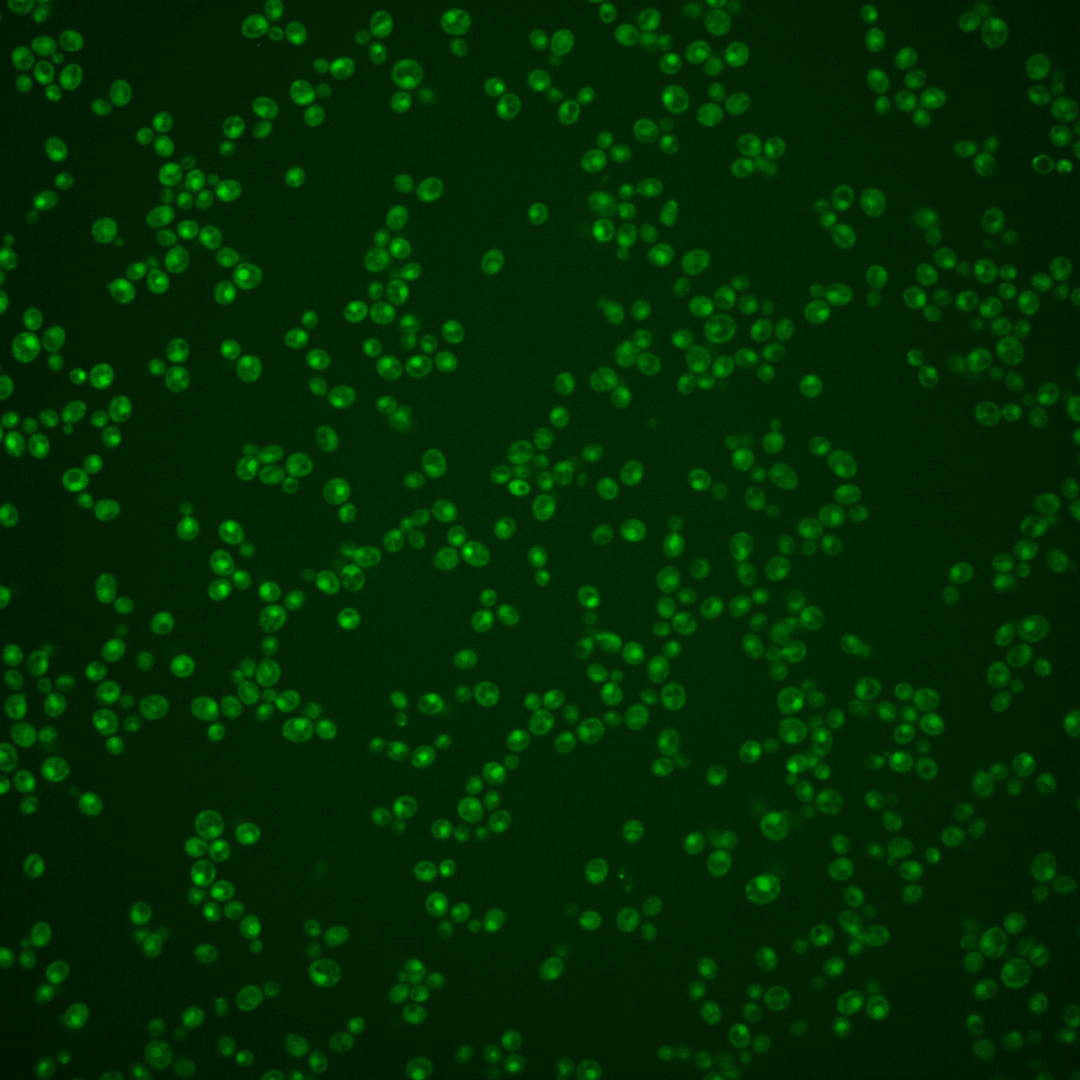
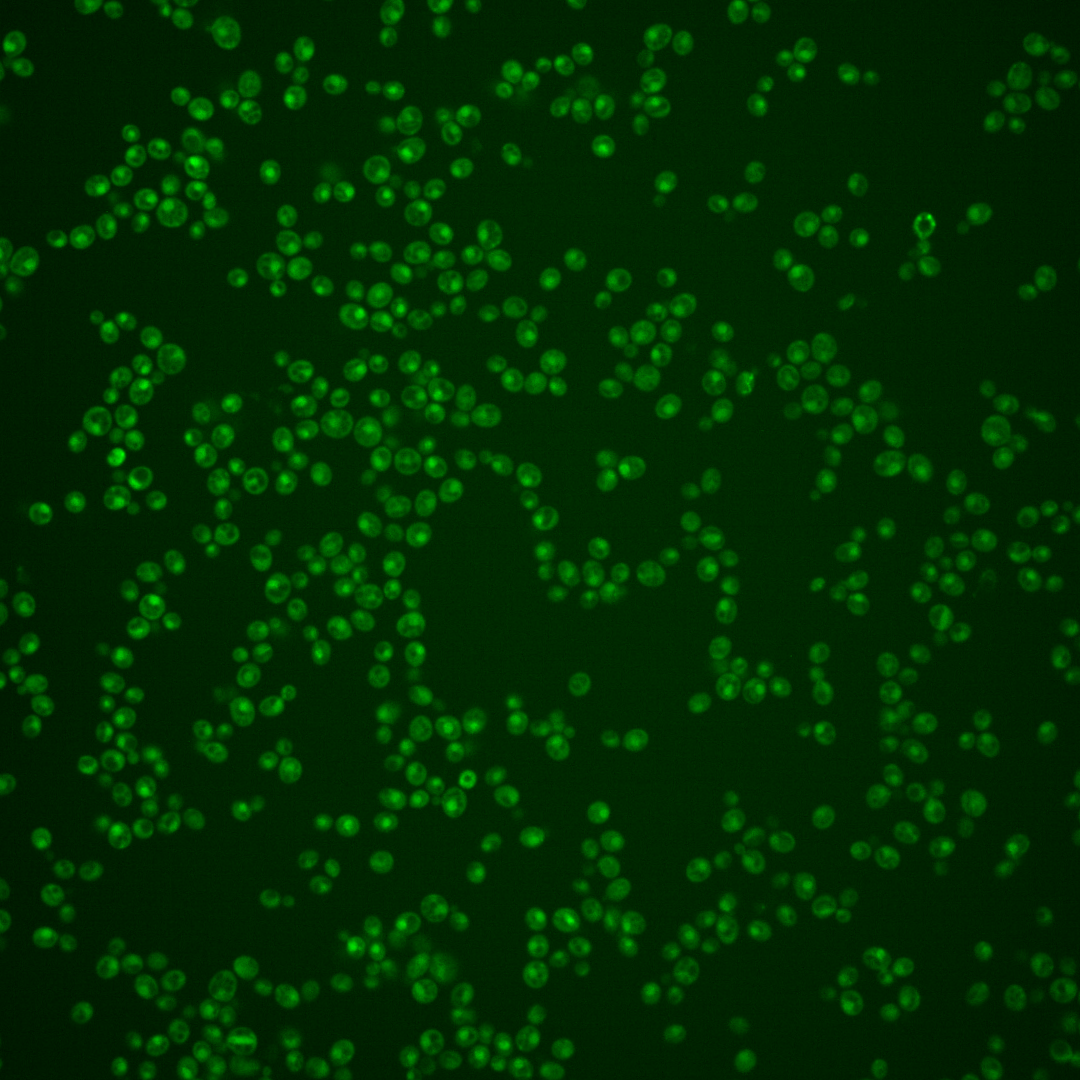
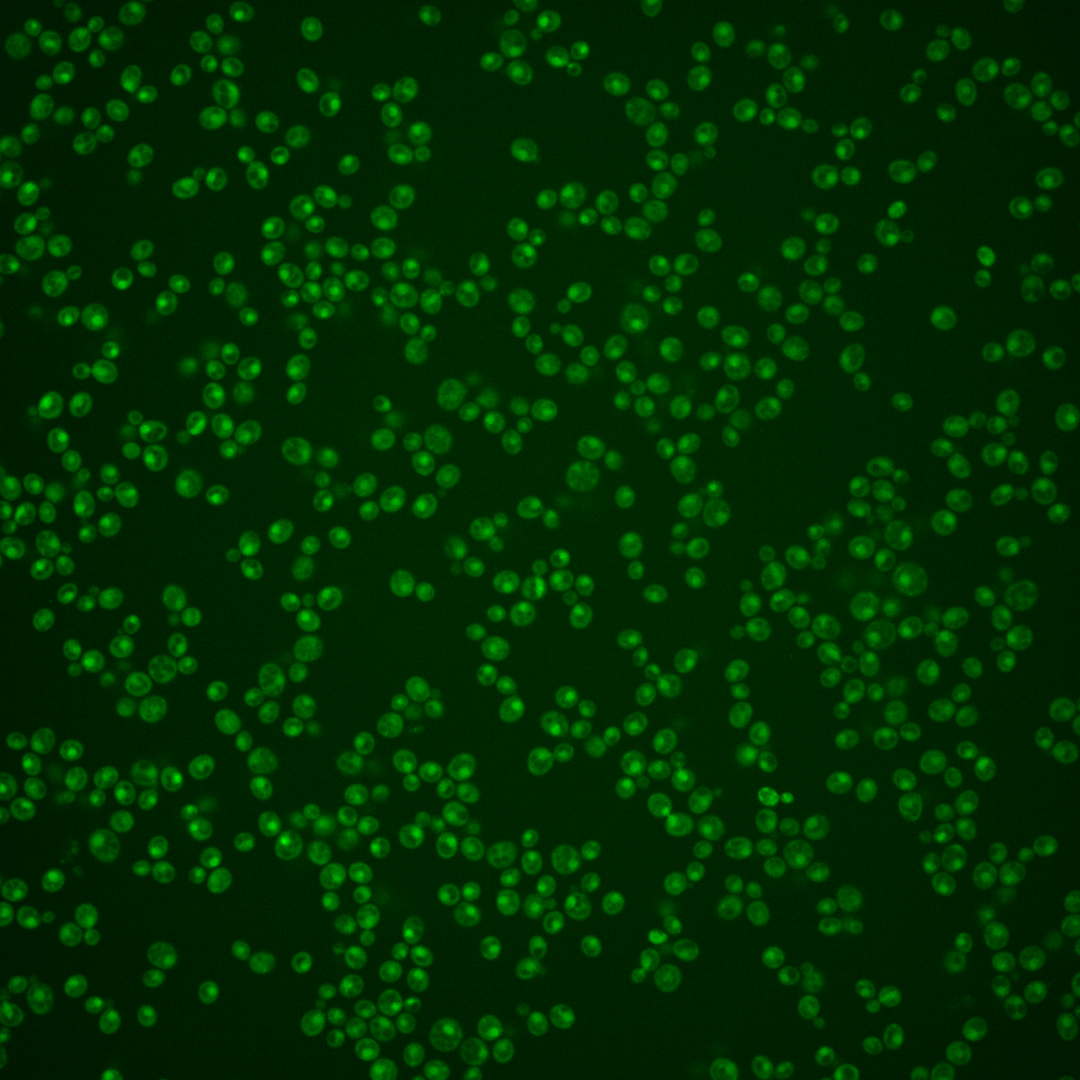

| Standard name | |
|---|---|
| Human Ortholog | |
| Description | Transcriptional repressor; mediates glucose repression and negatively regulates filamentous growth; activated in stochastic pulses of nuclear localization in response to low glucose |
Micrographs




















































































Sub-cellular Localization
Yeast GFP Assignment
Protein Abundance
Localization Change
External localization resources
| ensLOC | DeepLoc | |||||||||||||||||||||||
|---|---|---|---|---|---|---|---|---|---|---|---|---|---|---|---|---|---|---|---|---|---|---|---|---|
| Localization | WT1 | WT2 | WT3 | RAP60 | RAP140 | RAP220 | RAP300 | RAP380 | RAP460 | RAP540 | RAP620 | RAP700 | HU80 | HU120 | HU160 | rpd3Δ_1 | rpd3Δ_2 | rpd3Δ_3 | WT1 | WT2 | WT3 | AF100 | AF140 | AF180 |
| Cortical Patches | 0 | 0 | 0 | 0 | 0 | 0 | 0 | – | 0 | 0 | 0 | 0 | 0 | 0 | 0 | 0 | 0 | 0 | 2 | 1 | 3 | 0 | 6 | 2 |
| Bud | 0 | 0 | 0 | 0 | 0 | 4 | 0 | – | 4 | 4 | 6 | 8 | 0 | 0 | 0 | 0 | 0 | 2 | 6 | 3 | 3 | 4 | 12 | 18 |
| Bud Neck | 0 | 0 | 5 | 0 | 3 | 2 | 6 | – | 5 | 2 | 4 | 2 | 1 | 1 | 0 | 0 | 0 | 0 | 2 | 1 | 1 | 2 | 6 | 12 |
| Bud Site | 1 | 0 | 0 | 0 | 0 | 3 | 0 | – | 3 | 1 | 5 | 1 | 0 | 0 | 0 | 0 | 0 | 0 | – | – | – | – | – | – |
| Cell Periphery | 0 | 0 | 1 | 0 | 0 | 0 | 0 | – | 0 | 0 | 0 | 1 | 1 | 0 | 1 | 1 | 0 | 1 | 0 | 0 | 0 | 0 | 0 | 0 |
| Cytoplasm | 86 | 84 | 155 | 141 | 157 | 157 | 151 | – | 189 | 159 | 188 | 185 | 192 | 301 | 249 | 92 | 72 | 80 | 72 | 82 | 131 | 53 | 130 | 87 |
| Endoplasmic Reticulum | 1 | 2 | 2 | 0 | 0 | 0 | 0 | – | 1 | 3 | 1 | 0 | 1 | 0 | 0 | 7 | 1 | 8 | 0 | 0 | 2 | 2 | 4 | 3 |
| Endosome | 38 | 9 | 7 | 25 | 22 | 2 | 27 | – | 6 | 8 | 12 | 10 | 31 | 14 | 32 | 4 | 0 | 3 | 23 | 9 | 4 | 7 | 16 | 12 |
| Golgi | 1 | 0 | 0 | 0 | 0 | 0 | 0 | – | 0 | 0 | 0 | 0 | 1 | 1 | 1 | 0 | 0 | 0 | 5 | 1 | 1 | 2 | 3 | 1 |
| Mitochondria | 33 | 49 | 1 | 14 | 15 | 144 | 78 | – | 217 | 133 | 219 | 210 | 4 | 6 | 1 | 1 | 1 | 3 | 12 | 17 | 22 | 10 | 22 | 22 |
| Nucleus | 88 | 76 | 7 | 19 | 24 | 17 | 51 | – | 70 | 59 | 52 | 57 | 27 | 18 | 12 | 1 | 0 | 1 | 139 | 125 | 34 | 60 | 54 | 52 |
| Nuclear Periphery | 0 | 0 | 0 | 0 | 0 | 1 | 2 | – | 0 | 0 | 0 | 2 | 0 | 0 | 0 | 1 | 0 | 0 | 1 | 0 | 0 | 0 | 2 | 1 |
| Nucleolus | 1 | 0 | 0 | 0 | 0 | 2 | 0 | – | 0 | 1 | 1 | 0 | 0 | 0 | 0 | 1 | 0 | 0 | 7 | 6 | 1 | 4 | 5 | 8 |
| Peroxisomes | 0 | 0 | 0 | 0 | 0 | 0 | 1 | – | 0 | 1 | 0 | 0 | 0 | 1 | 0 | 0 | 0 | 0 | 0 | 0 | 0 | 0 | 0 | 0 |
| SpindlePole | 3 | 5 | 2 | 5 | 7 | 3 | 20 | – | 6 | 7 | 8 | 13 | 0 | 2 | 1 | 0 | 0 | 0 | 37 | 24 | 15 | 21 | 41 | 30 |
| Vac/Vac Membrane | 90 | 69 | 19 | 42 | 67 | 12 | 46 | – | 52 | 41 | 44 | 46 | 81 | 64 | 105 | 16 | 23 | 23 | 79 | 85 | 50 | 45 | 75 | 53 |
| Unique Cell Count | 299 | 259 | 191 | 222 | 265 | 291 | 330 | 461 | 366 | 456 | 456 | 299 | 384 | 340 | 103 | 87 | 104 | 404 | 371 | 287 | 225 | 397 | 321 | |
| Labelled Cell Count | 342 | 294 | 199 | 246 | 295 | 347 | 382 | 553 | 419 | 540 | 535 | 339 | 408 | 402 | 124 | 97 | 121 | 404 | 371 | 287 | 225 | 397 | 321 | |
Yeast GFP Assignment
Protein Abundance
| Screen | WT1 | WT2 | WT3 | RAP60 | RAP140 | RAP220 | RAP300 | RAP380 | RAP460 | RAP540 | RAP620 | RAP700 | HU80 | HU120 | HU160 | rpd3Δ_1 | rpd3Δ_2 | rpd3Δ_3 | AF100 | AF140 | AF180 |
|---|---|---|---|---|---|---|---|---|---|---|---|---|---|---|---|---|---|---|---|---|---|
| Mean Cell GFP Intensity (1e-4) | 4.2 | 4.0 | 4.9 | 4.8 | 5.1 | 3.6 | 4.3 | – | 3.6 | 3.9 | 3.7 | 3.9 | 5.1 | 4.6 | 5.6 | 5.7 | 6.0 | 5.5 | 4.4 | 4.7 | 5.1 |
| Std Deviation (1e-4) | 0.8 | 0.6 | 0.7 | 1.3 | 1.3 | 1.5 | 1.2 | – | 0.6 | 0.8 | 0.7 | 0.7 | 1.3 | 1.3 | 2.3 | 1.5 | 0.9 | 1.3 | 1.1 | 1.6 | 2.0 |
| Intensity Change (Log2) | – | – | – | -0.02 | 0.06 | -0.45 | -0.21 | – | -0.46 | -0.32 | -0.4 | -0.34 | 0.05 | -0.1 | 0.2 | 0.22 | 0.29 | 0.17 | -0.16 | -0.05 | 0.05 |
Localization Change
| Localization | RAP60 | RAP140 | RAP220 | RAP300 | RAP380 | RAP460 | RAP540 | RAP620 | RAP700 | HU80 | HU120 | HU160 | rpd3Δ_1 | rpd3Δ_2 | rpd3Δ_3 |
|---|---|---|---|---|---|---|---|---|---|---|---|---|---|---|---|
| Actin | – | – | – | – | – | – | – | – | – | – | – | – | – | – | – |
| Bud | – | – | – | – | – | – | – | – | – | – | – | – | 0 | 0 | 0 |
| Bud Neck | – | – | – | – | – | – | – | – | – | – | – | – | 0 | 0 | 0 |
| Bud Site | – | – | – | – | – | – | – | – | – | – | – | – | 0 | 0 | 0 |
| Cell Periphery | – | – | – | – | – | – | – | – | – | – | – | – | 0 | 0 | 0 |
| Cyto | – | – | – | – | – | – | – | – | – | – | – | – | – | – | – |
| Endoplasmic Reticulum | – | – | – | – | – | – | – | – | – | – | – | – | 0 | 0 | 0 |
| Endosome | – | – | – | – | – | – | – | – | – | – | – | – | 0 | 0 | 0 |
| Golgi | – | – | – | – | – | – | – | – | – | – | – | – | 0 | 0 | 0 |
| Mitochondria | – | – | – | – | – | – | – | – | – | – | – | – | 0 | 0 | 0 |
| Nuclear Periphery | – | – | – | – | – | – | – | – | – | – | – | – | 0 | 0 | 0 |
| Nuc | – | – | – | – | – | – | – | – | – | – | – | – | – | – | – |
| Nucleolus | – | – | – | – | – | – | – | – | – | – | – | – | 0 | 0 | 0 |
| Peroxisomes | – | – | – | – | – | – | – | – | – | – | – | – | 0 | 0 | 0 |
| SpindlePole | – | – | – | – | – | – | – | – | – | – | – | – | 0 | 0 | 0 |
| Vac | – | – | – | – | – | – | – | – | – | – | – | – | – | – | – |
| Cortical Patches | – | – | – | – | – | – | – | – | – | – | – | – | 0 | 0 | 0 |
| Cytoplasm | – | – | – | – | – | – | – | – | – | – | – | – | 0 | 0 | 0 |
| Nucleus | – | – | – | – | – | – | – | – | – | – | – | – | 0 | 0 | 0 |
| Vacuole | – | – | – | – | – | – | – | – | – | – | – | – | 1.4 | 3.6 | 2.9 |
External localization resources
Images






























Protein Concentration and Protein Localization Data
| R1 | R2 | R3 | ||||||||||||||||
|---|---|---|---|---|---|---|---|---|---|---|---|---|---|---|---|---|---|---|
| G1 Pre-START | G1 Post-START | S/G2 | Metaphase | Anaphase | Telophase | G1 Pre-START | G1 Post-START | S/G2 | Metaphase | Anaphase | Telophase | G1 Pre-START | G1 Post-START | S/G2 | Metaphase | Anaphase | Telophase | |
| Concentration | -0.9144 | -0.5731 | -0.8279 | -0.8957 | -0.9633 | -0.6042 | 0.6404 | 0.5375 | 0.7686 | -0.2443 | 0.4014 | 1.2574 | 2.8801 | 4.0503 | 3.5203 | 2.8474 | 4.343 | 3.6657 |
| Actin | 0.005 | 0.0004 | 0.0005 | 0.0023 | 0.008 | 0.001 | 0.0368 | 0.0002 | 0.0055 | 0.0003 | 0.001 | 0.0109 | 0.0096 | 0.0003 | 0.0101 | 0.0001 | 0.0006 | 0.0004 |
| Bud | 0.0031 | 0.0076 | 0.0028 | 0.0026 | 0.0065 | 0.0049 | 0.0005 | 0.0003 | 0.001 | 0.0001 | 0.0001 | 0.0005 | 0.0004 | 0.0008 | 0.0003 | 0.0001 | 0.0001 | 0.0002 |
| Bud Neck | 0.0055 | 0.0009 | 0.0009 | 0.0008 | 0.0037 | 0.0061 | 0.0008 | 0.0003 | 0.0009 | 0.0006 | 0.0025 | 0.0025 | 0.0009 | 0.0005 | 0.0007 | 0.0003 | 0.0003 | 0.0042 |
| Bud Periphery | 0.0013 | 0.0017 | 0.001 | 0.0018 | 0.0056 | 0.0018 | 0.0009 | 0.0003 | 0.0009 | 0.0001 | 0.0002 | 0.0008 | 0.0004 | 0.0009 | 0.0004 | 0 | 0.0001 | 0.0001 |
| Bud Site | 0.0061 | 0.0117 | 0.0051 | 0.0006 | 0.0035 | 0.0006 | 0.0028 | 0.0012 | 0.0068 | 0.0003 | 0.0006 | 0.0007 | 0.0012 | 0.0011 | 0.0009 | 0.0002 | 0.0002 | 0.0004 |
| Cell Periphery | 0.0003 | 0.0002 | 0.0001 | 0.0001 | 0.0003 | 0.0001 | 0.0002 | 0.0001 | 0.0002 | 0 | 0.0001 | 0.0001 | 0.0001 | 0.0001 | 0.0001 | 0 | 0.0001 | 0.0001 |
| Cytoplasm | 0.1511 | 0.2133 | 0.1637 | 0.1818 | 0.0851 | 0.1238 | 0.1962 | 0.2409 | 0.2559 | 0.2561 | 0.1913 | 0.1197 | 0.1861 | 0.2841 | 0.2605 | 0.3664 | 0.155 | 0.193 |
| Cytoplasmic Foci | 0.0362 | 0.0074 | 0.0174 | 0.0095 | 0.0259 | 0.0183 | 0.0158 | 0.0044 | 0.0116 | 0.0022 | 0.0057 | 0.0046 | 0.0074 | 0.0042 | 0.0065 | 0.0038 | 0.0033 | 0.0055 |
| Eisosomes | 0.0002 | 0.0001 | 0.0002 | 0 | 0.0004 | 0 | 0.0003 | 0.0001 | 0.0001 | 0 | 0.0001 | 0.0001 | 0.0001 | 0.0001 | 0.0004 | 0 | 0.0001 | 0 |
| Endoplasmic Reticulum | 0.0063 | 0.0041 | 0.0049 | 0.0024 | 0.0032 | 0.0018 | 0.0059 | 0.0043 | 0.0062 | 0.0035 | 0.0062 | 0.0047 | 0.0055 | 0.0049 | 0.0045 | 0.0043 | 0.0032 | 0.0028 |
| Endosome | 0.018 | 0.0044 | 0.0056 | 0.0048 | 0.0115 | 0.0035 | 0.032 | 0.0029 | 0.0073 | 0.0018 | 0.0092 | 0.0197 | 0.0078 | 0.0035 | 0.0072 | 0.0051 | 0.0057 | 0.0035 |
| Golgi | 0.0021 | 0.0001 | 0.0002 | 0.0002 | 0.0019 | 0.0001 | 0.0126 | 0.0001 | 0.0009 | 0 | 0.0004 | 0.0102 | 0.0018 | 0.0001 | 0.0019 | 0 | 0.0001 | 0.0001 |
| Lipid Particles | 0.0062 | 0.0006 | 0.0013 | 0.0004 | 0.0072 | 0.0005 | 0.0085 | 0.0002 | 0.0006 | 0.0001 | 0.0012 | 0.0045 | 0.0058 | 0.0002 | 0.0025 | 0.0001 | 0.0001 | 0.0003 |
| Mitochondria | 0.0026 | 0.0014 | 0.0016 | 0.0018 | 0.0055 | 0.0005 | 0.0135 | 0.0005 | 0.0008 | 0.0005 | 0.0012 | 0.0176 | 0.0018 | 0.0009 | 0.001 | 0.0003 | 0.0006 | 0.0006 |
| None | 0.2238 | 0.3174 | 0.2686 | 0.2206 | 0.1364 | 0.1627 | 0.387 | 0.4783 | 0.4558 | 0.1799 | 0.3956 | 0.2295 | 0.3475 | 0.4301 | 0.4626 | 0.1296 | 0.5715 | 0.2896 |
| Nuclear Periphery | 0.0254 | 0.0199 | 0.0206 | 0.0251 | 0.0319 | 0.011 | 0.011 | 0.0081 | 0.0114 | 0.01 | 0.0353 | 0.0187 | 0.0224 | 0.0114 | 0.0068 | 0.013 | 0.0059 | 0.0083 |
| Nucleolus | 0.0121 | 0.0055 | 0.0066 | 0.0055 | 0.0192 | 0.0084 | 0.0022 | 0.0015 | 0.0016 | 0.002 | 0.0106 | 0.0058 | 0.0031 | 0.0022 | 0.0013 | 0.0012 | 0.0013 | 0.007 |
| Nucleus | 0.4052 | 0.3249 | 0.3904 | 0.4015 | 0.4195 | 0.5369 | 0.2313 | 0.2421 | 0.208 | 0.5168 | 0.2853 | 0.5293 | 0.3478 | 0.223 | 0.2112 | 0.4606 | 0.2446 | 0.4277 |
| Peroxisomes | 0.0062 | 0.0002 | 0.0003 | 0.0006 | 0.0015 | 0.0002 | 0.0036 | 0.0001 | 0.0004 | 0.0001 | 0.0003 | 0.0012 | 0.0036 | 0.0001 | 0.0011 | 0 | 0.0001 | 0.0001 |
| Punctate Nuclear | 0.0775 | 0.0747 | 0.1046 | 0.1358 | 0.2201 | 0.1163 | 0.028 | 0.0113 | 0.0195 | 0.0234 | 0.0484 | 0.0155 | 0.0389 | 0.0265 | 0.0161 | 0.012 | 0.0025 | 0.054 |
| Vacuole | 0.0048 | 0.0033 | 0.0027 | 0.0011 | 0.0016 | 0.0014 | 0.0073 | 0.0025 | 0.004 | 0.0019 | 0.0041 | 0.0022 | 0.0063 | 0.0043 | 0.0032 | 0.0026 | 0.0042 | 0.0019 |
| Vacuole Periphery | 0.0011 | 0.0005 | 0.0007 | 0.0006 | 0.0015 | 0.0003 | 0.0028 | 0.0003 | 0.0007 | 0.0002 | 0.0008 | 0.0013 | 0.0012 | 0.0006 | 0.0006 | 0.0004 | 0.0006 | 0.0003 |
Sequencing Data
| R1 | R2 | |||||||||
|---|---|---|---|---|---|---|---|---|---|---|
| G1 Post-START | S/G2 | Metaphase | Anaphase | Telophase | G1 Post-START | S/G2 | Metaphase | Anaphase | Telophase | |
| Gene Expression | 9.1534 | 5.951 | 13.2477 | 22.6521 | 10.7889 | 6.6534 | 13.1623 | 23.8589 | 21.7285 | 13.9799 |
| Translational Efficiency | 0.7949 | 1.5778 | 1.1715 | 1.4908 | 0.9594 | 1.2729 | 1.0822 | 1.2145 | 1.5307 | 1.1962 |
Hit Data
| Dataset | Hit |
|---|---|
| Protein Concentration | ✘ |
| Protein Localization | ✘ |
| Gene Expression | ✔ |
| Translational Efficiency | ✘ |
Endocytosis
| Temp | Actin Patch (Sac6-tdTomato) | Cortical Patch (Sla1-GFP) | Late Endosome (Snf7-GFP) | Vacuole (Vph1-GFP) |
|---|---|---|---|---|
| 37℃ | ||||
| RT |
Cell Cycle Omics
CYCLoPs (Nrg2-GFP)
| Gene / Allele | Actin Patch (Sac6-tdTomato) | Cortical Patch (Sla1-GFP) | Late Endosome (Snf7-GFP) | Vacuole (Sac6-tdTomato) |
|---|
| Gene | Images |
|---|
| Gene | Images |
|---|
Images are not yet available
Images are not yet available